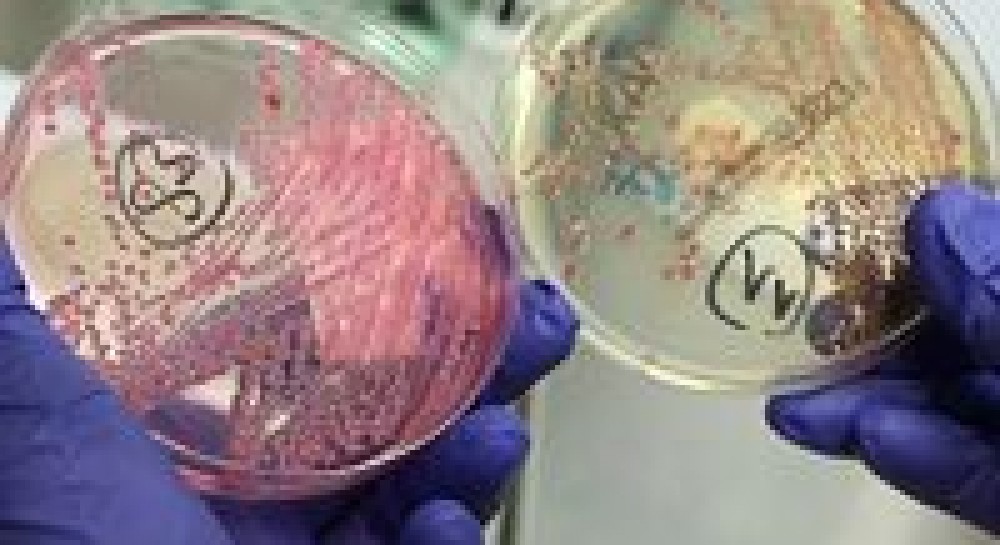
Можно ли избежать летних отравлений

Можно ли избежать летних отравлений
Заражение происходит при употреблении в пищу мяса больных животных, в которых бактериемия была спровоцирована тяжелой травмой, голоданием, сильной усталостью...
Среди бактериальных пищевых отравлений наибольшее распространение во всех странах мира имеют токсикоинфекции.
Само название показывает двойственный характер данных патологических состояний, которые обусловливаются, с одной стороны, массированным проникновением в организм возбудителей инфекции, а с другой стороны - комплексом клинических явлений, типичных для интоксикации.
Этиология этих отравлений наиболее часто связана с некоторыми представителями сальмонел. При проведении специальных исследований было установлено, что основную роль в патогенезе токсикоинфекции имеет поступление в желудочно-кишечный тракт живых микробов, причем продукты, даже обильно засеянные сальмонелами, после тщательной термической обработки не вызывают заболеваний. Передача в основном осуществляется через инфицированные пищевые продукты.
Во многих случаях заражение происходит при употреблении в пищу мяса больных животных или бацилоносителей, в которых бактериемия была спровоцирована тяжелой травмой, голоданием, сильной усталостью и т.д. Другим путем есть посмертное заражение животных, обусловленное несоблюдением правил забоя скота и обработки гаси, когда содержание кишечника попадает на ее поверхность.
Профилактика токсикоинфекций требует установления строгого ветеринарно-санитарного контроля на животноводческих фермах и бойнях и соблюдения общих гигиенических правил на предприятиях общественного питания. К мерам по предупреждению массивного размножения микроорганизмов в пищевых продуктах относят достаточное охлаждение и быструю реализацию готовых изделий, которая исключает задержку их в теплых помещениях кухни.
Особенным видом бактериальных пищевых отравлений является токсикозы - заболевания, обусловленные в отличие от токсикоинфекций проникновением в организм не живых микробов, а только их токсинов.
К этим отравлениям относятся стафилококковые интоксикации, вызываемые некоторыми штаммами белого и золотистого стафилококков, основными источниками которых могут служить молочный скот и человек. В первом случае причиной, как правило, является употребление в пищу молока коров, больных маститами, во втором инфицирование обусловливается разными гнойными поражениями кожи и ангинами. В этом отношении необходимо всегда помнить, что маленький гнойничок на руке у повара может стать причиной большой вспышки пищевых отравлений.
Часто эти интоксикации связывают с потреблением молочных или продуктов изделий из них, в частности мороженого и особенно заварного крема, причем последний служит как бы накоплением токсинов. Клиническая картина отравлений стафилококковым токсином характеризуется коротким инкубационным периодом - в среднем 2-4 ч, по окончании которого у потерпевших появляются тошнота, рвота, резкие боли в подложечной области и понос. Температура обычно не повышается, а иногда даже отмечается ее снижение.
Выздоровление же, невзирая на внешнюю важность заболевания, обычно наступает на протяжении первых суток. В виде того, что стафилококковый энтеротоксин есть теплостойким и выдерживает 30-минутное кипячение, основой профилактических мероприятий является высокий уровень санитарного благоустройства пищевых предприятий, которое устраняет опасность бактериального заражения оборудования, продуктов и готовых изделий.
Одним из наиболее тяжелых пищевых отравлений есть ботулизм, случаи которого регистрируются во всех странах мира. Доказано, что это очень опасное заболевание вызывается токсином анаэробной бациллы долгосрочного жителя почвы. По своей биологической активности он превосходит все известные токсины других микробов. По клинической картине ботулизм являет собой своеобразное заболевание с нервно-паралитическим синдромом. После инкубационного периода, в среднем ровного 12 - 24 ч (но иногда продлевается до нескольких суток), развиваются нервно-двигательные и секреторные расстройства. К ранним симптомам интоксикации обычно относятся явления офтальмоплегии в виде расширения зениц, диплопии, отсутствия реакции на свет и др. В дальнейшем может отмечаться паралич мышц мягкого неба, языка, глотки и гортани, который усложняет акты глотания и жевания. Продолжаясь 4-8 дней, заболевание отличается высокой летальностью (до 67%), причем смертельный исход бывает связан с остановкой дыхательной или сердечной деятельности. Применяемая в настоящее время специфическая сывороточная терапия при раннем ее применении снижает летальность приблизительно до 13%.
К микробным пищевым отравлениям относятся и так называемые микотоксикозы, которые представляют собой заболевания, обусловленные продуктами жизнедеятельности микроскопических грибов. Классическим примером данной группы отравлений служит эрготизм, который вызывается употреблениям некоторых продуктов растительного происхождения, зараженных микотоксином рожка. Чаще всего этот микроскопический гриб будет поражать рожь, реже - пшеницу и ячмень, причем ядовитою его основой является группа алкалоидов (эрготамин, эргометрин, эргобазин и др.), стойких к нагреванию и которые хранят свою токсичность при выпечке хлеба.
К числу пищевых отравлений, визываемых микроскопическими грибами, стоит отнести и группу фузариотоксикозов, в частности алиментарно-токсичную алейкию. Это тяжелое заболевание возникает при употреблении зерна перезимованых на корне злаков, интенсивно зараженных грибами из рода фузариум. В основе данного патологического состояния лежит поражение центральной нервной системы, которая обусловливает нарушение трофики тканей и резкое расстройство деятельности органов кровообразования. В итоге у потерпевших развивается притеснение гемопоэза с последующей алейкией и выраженной анемией. Внешними признаками заболевания могут служить некротическая (септическая) ангина и другие тяжелые осложнения, обусловленные ареактивностью организма. Очень большое внимание органов здравоохранения уделяется в данное время афлатоксикозам, которые вызываются специфическими токсинами, владеющими самым сильным гепатотропным и канцерогенным влиянием.
Леонид Базуков,
врач-гастроэнтеролог